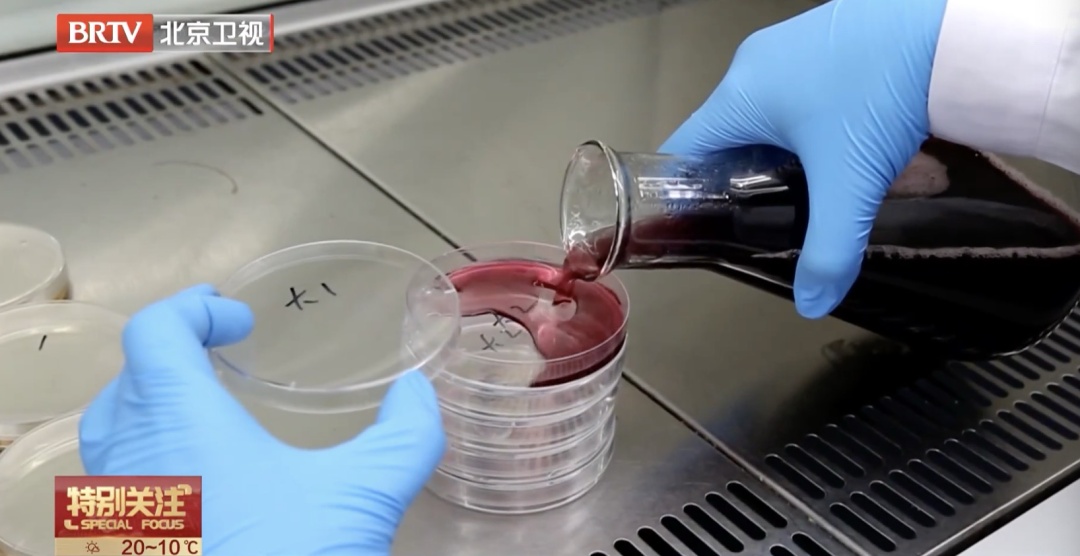
有这个标识的三文鱼，千万别生吃！专家提醒——

最近,关于“超市三文鱼能否生食”的话题在网络上引起热议。不少市民反映,在超市购买的冰鲜三文鱼,但包装上却写着“加热后烹饪食用”。这到底是怎么回事?
3月29号晚,记者来到位于昌平区的山姆会员店,在冷藏三文鱼专柜,记者看到这里集中售卖的一款冰鲜三文鱼,单价每500克109元,其直观上看冷鲜包装色泽诱人,看起来和日料店的刺身一模一样,但是包装上却明确写着“加热后食用”。
山姆会员店店员说:“我们不建议生吃,但是90%的人都选择生吃。”

这名店员起初明确表示“可以生吃”,并称“90%的人都是生吃”。但当记者追问为何包装注明需加热时,该店员称是因为执行标准“不符合生食食品国家标准”,这款说明为“加热后食用”的三文鱼标明执行的标准是GB 2733-2015(不可生食)。他最终给出的建议是:“看个人选择”。
山姆会员店店员说:“看您个人,我们买回去也是生吃,因为一直都是生吃,也没有问题,东西还是这个东西。”
随后,记者又来到了盒马超市清河店,店内同样设有一个三文鱼专卖店,与山姆店不同的是,这里明确标注所售卖的三文鱼执行标准是GB 10136-2015,明确可生食。
盒马超市工作人员说:“可以生食,都是能蘸送的酱吃的。”
专柜内也有标注为加热后食用的三文鱼,不过并非三文鱼肉,而是三文鱼头和鱼骨内,执行标准为GB 2733-2015。

在对两家超市的走访中,针对同一类产品,记者便得到了“可生吃”、“不建议但很多人吃”、“不能生吃”三种截然不同的答案。这不仅暴露出店员自身对产品属性及安全规范缺乏统一、准确的培训,也让消费者感到困惑。在采访中记者发现,消费者在如何挑选三文鱼方面,积累了不少直观经验,但对产品包装上的关键执行标准认知较为模糊。
有消费者说:“一般会选那种能生食的,我们家主要是生食,执行标准听说有能生食和不能生食两种区别,但是没有仔细关注过。”
生食三文鱼:
认准“可生食”标识与产品标准是关键
目前,市面上的三文鱼主要涉及两项食品安全国家标准,分别是GB 2733-2015《食品安全国家标准 鲜、冻动物性水产品》和GB 10136-2015《食品安全国家标准 动物性水产制品》。两者虽仅一字之差,但对食品安全的要求却有本质区别。

北京市食品检验研究院生物学检测研究室副主任胡智恺介绍:“GB 2733-2015属于原料级标准,适用于鲜的或冻的动物性水产品,默认消费者购买后会加热后熟制食用,因此没有对寄生虫和微生物指标做强制要求,执行GB 2733-2015的三文鱼,只能说明这是一条安全干净的原料鱼,不能生吃。 ”
而GB 10136-2015标准中,则专门包含了“即食生食动物性水产品”这一类别。生产此类产品的企业,需要遵循更严格的加工规范,通常包含专门的清洗、消毒等工艺,并需经过出厂检验合格后方可上市。因此,执行GB 10136-2015标准是产品能够安全生食的重要保障。
胡智恺介绍:“判断三文鱼能不能生吃的关键,不是看起来新不新鲜,而是是否严格执行了国家标准,如果写着GB 10136-2015,或者在包装上写着‘可以生食’、‘开袋即食’,就可以直接吃,如果上边写着加热后烹饪食用,就不要直接吃。”
针对“食用生鲜时蘸取芥末、酱油可以杀死寄生虫”的常见误区,专家也予以澄清:芥末只有在高浓度下并长时间浸泡,如45分钟以上时,才有可能杀灭离体的寄生虫幼虫。

胡智恺介绍:“咱们在吃生鲜的时候蘸的芥末和酱油,主要的目的还是减少腥味,不能够代替科学的食品安全管控的措施。”
据长期的市场监测结果反馈,执行GB 10136-2015标准的可生食三文鱼,其微生物指标和寄生虫风险的检测合格率整体维持在很高水平,产品质量稳定可靠。而执行GB 2733-2015标准的三文鱼在零售市场已较为少见。消费者只需在购买时留意包装标识与执行标准,选择正规渠道购买标识清晰的产品,即可安心享受生食三文鱼的美味,无需过度恐慌。
转发提醒家人!
BRTV新闻(记者:白雪微 郝欣)
点击右上角
微信好友
朋友圈

点击浏览器下方“
”分享微信好友Safari浏览器请点击“
”按钮

点击右上角
QQ

点击浏览器下方“
”分享QQ好友Safari浏览器请点击“
”按钮
